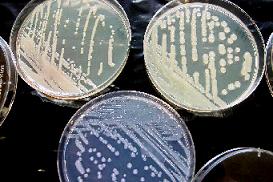
Aspecto del crecimiento de Erwinia amylovora en los medios de cultivo

[5/8/10]
El programa nacional de erradicación y control del fuego bacteriano, enfermedad provocada por la bacteria Erwinia amylovora en rosáceas, implica la realización de prospecciones sistemáticas, tanto en viveros como en campo. Como resultado de ello, llegan al Laboratorio dos tipos de muestras:
El diagnóstico de esta bacteria en el Laboratorio Regional se lleva a cabo siguiendo las directrices marcadas en el Protocolo de diagnóstico de 2004 de la EPPO (Organización Europea y Mediterránea para la Protección de las Plantas).
Para las muestras sin síntomas, se realizan siembras en los medios de cultivo recomendados por la EPPO, y una posterior caracterización bioquímica de los cultivos bacterianos obtenidos. También se realizan pruebas serológicas (ELISA enriquecido) que permiten la detección de la bacteria cuando ésta se encuentra en una concentración muy pequeña dentro de la planta. Hasta el momento, el Laboratorio no ha detectado la bacteria en muestras procedentes de viveros.
Para las muestras con síntomas, se toman porciones de material vegetal que incluyan la zona de avance de la enfermedad y se realizan siembras en los medios de cultivo. Una vez se obtiene crecimiento bacteriano, se procede a su identificación y caracterización bioquímica. Como pruebas confirmatorias, se utilizan pruebas serológicas (ELISA o Inmunoinfluorescencia) o moleculares (Nested PCR a tiempo real). Por último, se comprueba el poder patógeno de la bacteria aislada mediante inoculación de la misma en peras sanas, comprobando que se reproducen los síntomas.
I- Aspecto del tejido de una rama de peral afectada por Erwinia amylovora. II- Aspecto del crecimiento de Erwinia amylovora en los medios de cultivo.
Cuando se detecta un foco de esta enfermedad por primera vez, al ser Erwinia amylovora una bacteria de cuarentena, es necesaria la confirmación de nuestros resultados por el Laboratorio de Bacteriología del Instituto Valenciano de Investigaciones Agrarias de Moncada, Laboratorio de Referencia de Bacterias Fitopatógenas a nivel nacional.
Este Laboratorio de Referencia, colaborando en el proyecto de EUPHRESCO "Desarrollo y validación de nuevos instrumentos de diagnóstico del fuego bacteriano", ha organizado un Ring test cuyo objetivo es evaluar las técnicas recientemente desarrolladas para la detección de E. amylovora en comparación con las descritas en el Protocolo de la EPPO de 2004, para incluirlas en una nueva versión de este protocolo. Varios laboratorios de los cinco continentes han sido invitados a participar en este Ring test, entre ellos el Laboratorio Regional de La Rioja.
El Ring test se ha llevado a cabo durante el primer semestre de este año. El ensayo se ha realizado sobre un total de once muestras, aplicando diferentes tipos de técnicas:
Los resultados de este ensayo serán evaluados por el organismo organizador del mismo, y la participación del Laboratorio Regional en él nos ha servido para validar las técnicas hasta ahora utilizadas en la detección y diagnóstico de la bacteria de cuarentena Erwinia amylovora.